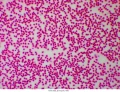
mikroskop-stereoskopowy-delta-optical-genetic-pro-bino-19.webp

Producenci
Producenci
Mikroskop stereoskopowy Delta Optical Genetic Pro Bino
 Opis
Opis
Delta Optical to uznany polski producent urządzeń optycznych. Delta Optical Genetic Pro jest jedną z najbardziej znanych serii mikroskopów Delta Optical. Rodzina mikroskopów Genetic Pro oferuje bardzo szeroki zakres zastosowań. Mikroskop optyczny Delta Optical Genetic Pro Bino to profesjonalny mikroskop stereoskopowy. Projekcja obrazu stereoskopowego znacząco podnosi komfort prowadzenia badań. Bardzo dobrej jakości optyka w mikroskopie stereoskopowym zapewnia ostry obraz. Delta Optical mikroskop posiada 4 achromatyczne obiektywy montowane na głowicy rewolwerowej. Dzięki tym obiektywom mikroskop oferuje powiększenia 10x, 40x, 400x, 1000x.

Stolik mikroskopowy w Delta Optical mikroskop
Preparaty umieszczane są na stoliku mikroskopowym o wymiarach 142 x 132 mm. Stolik wyposażony został w skalę z podziałką noniusza. Pozwala ona uzyskać dużą precyzję regulacji położenia. Stolik przystosowano do umieszczenia 2 preparatów. Położenie stolika produktu regulowane jest za pomocą śrub makro i mikrometrycznej. Regulacja dla obu pokręteł odbywa się współosiowo. Najmniejszy precyzyjny ruch dla regulacji mikro to 4 µm.
Możliwości rozbudowy prezentowanego mikroskopu optycznego
Często przed zakupem zadajemy sobie pytanie o rozbudowę mikroskopu. Producent do serii Delta Optical Genetic Pro oferuje bogatą bazę akcesoriów mikroskopowych. Pozwala ona w przyszłości znacznie rozszerzyć możliwości mikroskopu optycznego. Należą do nich takie produkty jak:
- Suchy kondensor ciemnego pola,
- Olejowy kondensor ciemnego pola,
- Zestaw do prostej polaryzacji,
- Tarczowy zestaw kontrastu fazowego,
- Bardziej zaawansowane okulary do mikroskopu.
Produkt występuje również w wersji z głowicą monokularową oraz trinokularową. Delta Optical Warszawa
Zastosowanie mikroskopu optycznego Delta Optical Genetic Pro
- Przychodnie weterynaryjne,
- Laboratoria medyczne,
- Laboratoria uczelni wyższych,
- Laboratoria szkół podstawowych i średnich,
- Sadownictwo.
Jeśli chodzi o wyposażenie laboratoriów szkolnych, mikroskop uzyskał zalecenie MEN.
Zalecenie numer 2432/2009 następującej treści:
Mikroskop biologiczny zalecany do użytku szkolnego przez Ministerstwo Edukacji Narodowej.
Wpisany do wykazu środków dydaktycznych przeznaczonych do kształcenia ogólnego. Nauczania biologii na poziomie szkoły podstawowej oraz liceum ogólnokształcącego. W zakres nauczania zarówno podstawowym, jak i rozszerzonym. Ponadto w liceach profilowanych oraz technikach.
Zalecenie wydano na recenzji rzeczoznawców:
- prof. dr hab. Danuty Cichy, zarekomendowanej przez Instytut Badań Edukacyjnych,
- dr. Wiktora Dżygóry, zarekomendowanego przez Akademię Wychowania Fizycznego w Katowicach.
Cechy produktu mikroskop stereoskopowy Genetic Pro Bino
- Mikroskop stereoskopowy - głowica binokularowa,
- Powiększenie mikroskopu optycznego w zakresie 40x - 1000x,
- W zestawie z mikroskopem stereoskopowym 4 achromatyczne obiektywy,
- Możliwość rozbudowy Delta Optical mikroskop o inne techniki obserwacji mikroskopowej,
- Szerokopolowe okulary 10x,
- Technika obserwacji jasnego pola, dobre oświetlenie typu LED,
- Kondensor Abbego N.A. 1.25.

Opis mikroskopu Delta Optical Genetic Pro Bino
- Producent: Delta Optical,
- Seria: Delta Optical Genetic Pro,
- Rodzaj mikroskopu: Mikroskop biologiczny,
- Typ mikroskopu: Mikroskop stereoskopowy,
- Technika obserwacji: Jasne pole,
- Technologia oświetlenia: LED,
- Typ oświetlenia: Światło przechodzące,
- Głowica obiektywowa: binokularowa, czteroobiektywowa,
- Okular mikroskopowy: Powiększenie 10x - 2 sztuki,
- Pole widzenia okularów: 18 mm,
- Rodzaj obiektywów: achromatyczne,
- Powiększenie obiektywów: 4x, 10x, 40x, 100x,
- Powiększenia mikroskopu wynikające z wyposażenia: 40x, 100x, 400x, 1000x,
- Kondensor: Tak, Abbego N.A. 1.25,
- Regulacja ostrości: Śruba makro metryczna i mikrometryczna - współosiowe,
- Minimalny ruch dla śruby mikrometrycznej: 4 µm
- Korekcja: 160 mm,
- Regulacja rozstawu okularów: 48 - 75 mm,
- Regulacja dioptrii: Tak, +/- 5D w lewym okularze,
- Mechanizm przesuwu preparatu: Stolik mikroskopowy na dwa preparaty z noniuszem,
- Wymiary stolika mikroskopowego: 142 x 132 mm,
- Zakres ruchu preparatu: 75 x 40 mm,
- Możliwości rozbudowy: Tak,
- Zakres rozbudowy: Ciemne pole, kontrast fazowy, polaryzacja,
- Zasilanie mikroskopu: Zasilacz napięcia stałego DC 5V, 500mA,
- Gwarancja: 24 miesiące.
Zawartość zestawu Delta Optical Genetic Pro Bino
- Mikroskop stereoskopowy Delta Optical Genetic,
- Obiektywy achromatyczne 4x, 10x, 40x, 100x,
- Okulary 10x,
- Filtr zielony,
- Olejek immersyjny,
- Kabel zasilający,
- Pokrowiec do przechowywania i transportu.
Obrazy z mikroskopu stereoskopowego Optical Genetic Pro
1. Wiązki przewodzące w łodydze 100x 2. Meteoryt - szlif, światło spolaryzowane, 40x


3. Wiązki przewodzące w łodydze 400x, jasne pole 4. Okrzemki, jasne pole, 100x


 Dane techniczne
Dane techniczne
| Rodzaj mikroskopu | Optyczny |
| Przeznaczenie mikroskopu | Laboratoria medyczne, przychodnie weterynaryjne, laboratoria akademickie, laboratoria szkolne, sadownictwo |
| Poziom zaawansowania | Mikroskop profesjonalny |
| Typ mikroskopu | Stereoskopowy |
| Rodzaj głowicy | Rewolwerowa |
| Ilość obiektywów głowicy | 4, achromatyczne |
| Powiększenie obiektywów [x] | 4, 10, 40, 100 |
| Powiększenie minimalne [x] | 40 |
| Powiększenie maksymalne [x] | 1000 |
| Tubus zewnętrzny | Tak |
| Powiększenie tubusu [x] | 1.0 |
| Ilość okularów w zestawie | 2 |
| Model i powiększenie okularu | WF10x - 10x |
| Regulacja ostrości | Ręcznie - śruba makrometryczna, śruba mikrometryczna |
| Pozycjonowanie preparatu | Ręczne - stolik z łapkami i podziałką noniusza |
| Technologia podświetlenia | LED |
| Sposoby podświetlenia | Górne |
| Zasilanie | Zasilacz DC 5V, 0.5A |
| Kamera PC | Nie (opcjonalnie) |
| Kolor | Biały (z czarnymi wykończeniami) |
| Wymiary [mm] | 290 x 145 x 100 |
| Waga [ kg] | 5.9 (z akcesoriami) |
| Informacje dodatkowe | Kondensor Abbego N.A. 1.25, regulacja dioptrii +/- 5D |
| Gwarancja | 24 miesiące |